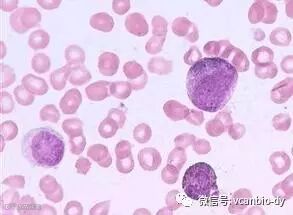

“非常庆幸当初生二胎时保存了脐带血,如今才能有机会救大女儿。希望妈妈们都能为孩子存一份脐血,关键时刻能救命呀。”2017年8月1日上午,在陆军总医院的移植病房外,看到二女儿的脐带血造血干细胞在医务人员的呵护下成功移植到大女儿小婷(化名)体内,小婷的母亲留下了激动的泪水。
就在这一天,陆军总医院与中源协和旗下天津市脐血库联手,为身患再生障碍性贫血的女孩小婷成功进行了同胞间的造血干细胞移植,为孩子送去了生命的希望。

花季女孩不幸患病
11岁的小婷本是一个美丽开朗的女孩,2008年底孩子出现流鼻血的症状,辗转多家医院诊疗,最终在2009年3月被确诊为再生障碍性贫血。
再生障碍性贫血简称再障,是一组由多种病因所致的骨髓造血功能衰竭性综合征,以骨髓造血细胞增生减低和外周血全血细胞减少为特征,临床以贫血、出血和感染为主要表现。确切病因尚未明确,再障发病可能与化学药物、放射线、病毒感染及遗传因素有关。通过造血干细胞移植可以有效治疗再生障碍性贫血。
目前,造血干细胞移植方式大致有三种,即:骨髓造血干细胞移植、外周血造血干细胞移植和脐带血造血干细胞移植。随着脐带血移植临床应用的增加,与骨髓移植相比,脐带血造血干细胞移植有两个明显的优势:冷冻保存的脐带血在实物库中,当需要应用时很快就能获得,不会延误移植时间;与无血缘关系成人供者造血干细胞移植相比,自体脐带血的基因和配型完全相合,不会出现移植后移植物抗宿主反应和排斥现象。因此,相对于其他造血干细胞移植方式脐带血造血干细胞最具优势 。
为了救女儿,小婷的父母在医生的建议下再次怀孕,并于分娩时在天津市脐血库为孩子保存了脐带血,为大女儿小婷留下了生命的火种。
脐带血点燃生命的希望
经检测,妹妹的脐带血配型与姐姐完全相合,完全达到移植标准。医生确定为小婷进行脐带血造血干细胞移植,2017年8月1日,在天津市脐血库工作人员一路精心呵护下,珍存小婷妹妹脐血的液氮罐安全抵达陆军总医院。上午10点,在医院与天津市脐血库的配合下,妹妹的脐带血顺利的移植到了姐姐的体内,开始在姐姐的体内“生根发芽”,发挥自己的“洪荒之力”,为姐姐赶走病魔。

看到女儿“重获新生”,小婷的母亲激动不已,更庆幸当初存储了二女儿的脐带血。“虽然我女儿不幸患病,但她却是幸运的,还有妹妹的脐血可以救她。“小婷母亲说,自从孩子患病以来,她看到过太多和小婷一样罹患血液疾病急需造血干细胞移植的孩子,但因为找不到配型相合的干细胞,家长们只能眼睁睁看着孩子的病情每况愈下,那种情形特别令人绝望。为此,小婷母亲希望能够向更多妈妈呼吁,“只要有机会、只要有条件,一定要为孩子存脐血,因为这是花再多钱也买不到的希望。”
延伸阅读
脐带血
新生儿脐带被结扎后存留在脐带和胎盘中的血液,这些血液中含有大量的造血干细胞。与骨髓干细胞和外周血干细胞相比,脐带血造血干细胞的免疫原性低,再生能力和速度是前者的10-20倍,已经越来越广泛用于临床治疗。世界脐带血库联盟数据表明,脐带血已成为造血干细胞临床移植术的新选择。
不仅救自己,更能救家人
无关供体间配型相合的几率仅为15-20万分之一。自体脐带血储存,对同族亲属来讲,有1/4-1/2配型相合几率,而且自存自用的脐带血是不需要配型的,并且没有免疫排斥反应。正是由于小婷的母亲将妹妹的脐带血存下,才得以挽救小婷的生命。
每一份珍贵的脐带血造血干细胞,都承载着家人无限的爱与希望。我们也衷心祝愿小婷能早日康复,和所有健康的小朋友一样拥有一个健康快乐的童年。孩子加油,中源协和将守护你的健康平安!






